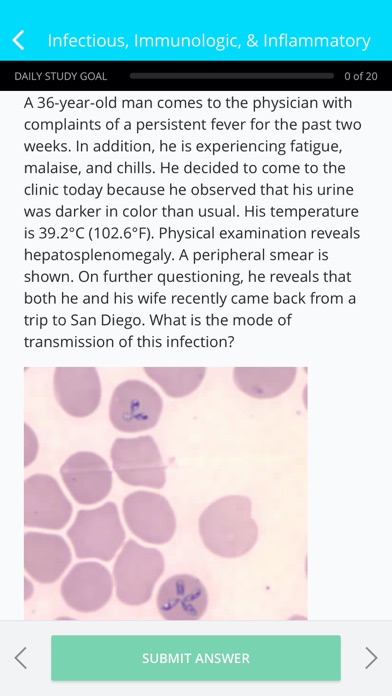

My Medical Mastery Exam Prep
iOS Universel / Education
Whether you preparing for USMLE Step 1 or 2, PANCE or PANRE exams, a membership to My Medical Mastery will support you in school, preparing for the exam and beyond.
WANTING TO BECOME A PHYSICIAN?
Gain the confidence you need to pass Step 1 or Step 2! Start a membership and receive:
Subscribe today and get access to:
• 3,200+ practice questions with explanations, including
• 1,150+ basic science questions to support you in school before the USMLE
• 1,200+ vignette-style questions for USMLE Step 1
• 800+ vignette-style questions for USMLE Step 2
• 28+ hours of audio/video content, including heart/lung sounds and high-yield lectures.
• 250+ mnemonics
• 500+ definitions
• 60+ generic drug flashcards
• 1 Month: one auto-renewing payment of $4.99
• 12 Months: one auto-renewing payment of $29.99
WANTING TO BECOME A PHYSICIAN ASSISTANT?
Ace your PANCE or PANRE exam with Physician Assistant Exam Prep! Featuring 700+ patient Vignette Questions, 920+ practice questions, and 250+ cardiovascular questions.
Get your best value by subscribing to the Premium Version. This includes access to:
• 1600+ exam-like practice questions with explanations and pictures
• Build your own custom quizzes
• 250+ cardiovascular questions
• 1 Month: one auto-renewing payment of $14.99
• 12 Months: one auto-renewing payment of $59.99
Let My Medical Mastery help you achieve the results you have been working towards!
-Payment will be charged to your iTunes Account at confirmation of purchase
-Subscription automatically renews unless auto-renew is turned off at least 24-hours before the end of the current period
-Your account will be charged for renewal within 24-hours prior to the end of the current period, and identify the cost of the renewal
-Subscriptions may be managed by the user and auto-renewal may be turned off by going to the user's Account Settings after purchase
-Any unused portion of a free trial period, if offered, will be forfeited when the user purchases a subscription to that publication, where applicable
These prices are for United States customers. Pricing in other countries may vary and actual charges may be converted to your local currency depending on the country of residence.
Our Customer Success Team is available from 9am to 5pm, Monday - Friday (except on major holidays). Call us at 319-246-5271 and email us at support@hltcorp.com with any questions.
Privacy Policy - http://builtbyhlt.com/privacy
Terms of Conditions - http://builtbyhlt.com/EULA
Quoi de neuf dans la dernière version ?
This version includes a few improvements to make your experience smoother.
Let us know what you think by emailing us at feedback@hltcorp.com or by leaving a 5-star review.